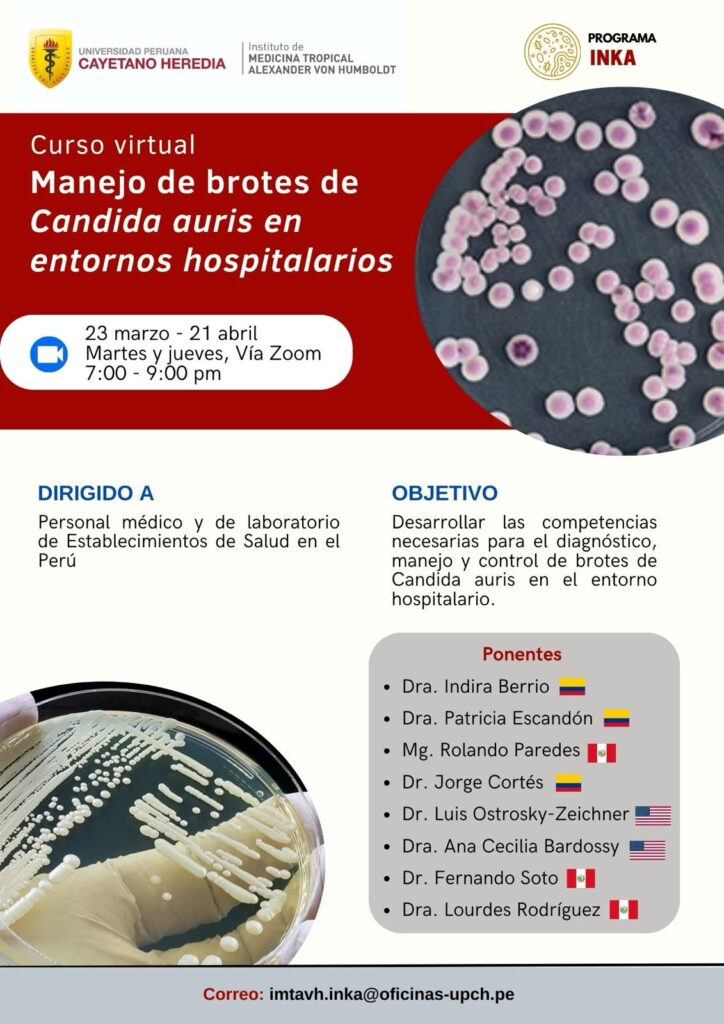

El curso “Manejo de brotes de Candida auris en entornos hospitalarios”, organizado por el Instituto de Medicina Tropical Alexander von Humboldt (IMTAvH), tiene como objetivo desarrollar competencias para el diagnóstico, manejo y control de brotes de Candida auris en establecimientos de salud del Perú.
El programa aborda aspectos clínicos, microbiológicos y epidemiológicos, fortaleciendo las capacidades del personal médico y de laboratorio para implementar estrategias efectivas de vigilancia, prevención y control frente a este patógeno multidrogorresistente.
Se desarrollará en modalidad virtual, con una duración de 16 horas (11 sincrónicas y 5 asincrónicas), e integra sesiones teóricas, análisis de casos clínicos y espacios interactivos orientados a la aplicación práctica de los contenidos.
DIRIGIDO A:
Personal médico y de laboratorio (licenciados/as de enfermería, tecnólogos médicos, biólogos, microbiólogos) de Establecimientos de Salud en el Perú.
PONENTES:
El curso contará con la participación de destacados ponentes nacionales e internacionales, quienes poseen amplia trayectoria y reconocida experiencia en los ámbitos clínico, microbiológico y epidemiológico vinculados a Candida auris. Su experiencia y conocimiento especializado garantizarán una formación actualizada, rigurosa y alineada con las mejores prácticas y recomendaciones internacionales para el abordaje de brotes en entornos hospitalarios.
INFORMACIÓN ADICIONAL:
| Organizado por: | Unidad de Micología Clínica (Programa INKA) – IMTAvH |
| Modalidad: | Virtual – Gratuito |
| Fecha: | Del 23 de marzo al 21 de abril del 2026 |
| Horario: | 7:00 p.m. a 9:00 p.m. (Hora peruana) 16 horas (11 sincrónicas y 5 asincrónicas) |
| Ficha de incripción: | https://forms.gle/p26M1FtQ5k7kbLSi9 |
CONSULTAS:
imtavh.inka@oficinas-upch.pe
imtavh.docencia@oficinas-upch.pe


